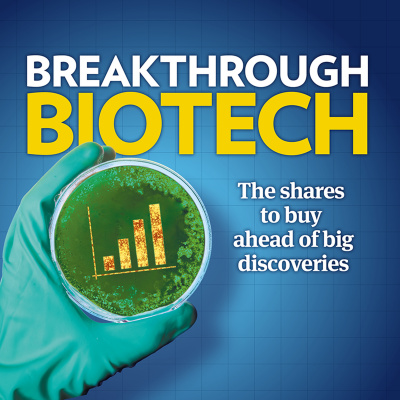
Investors Chronicle

Investors Chronicle
Companies & Markets Show 8 July 2016
- Autor: Vários
- Narrador: Vários
- Editor: Podcast
- Duración: 0:34:24
- Mas informaciones
Informações:
Sinopsis
Property pain and biotech gain: why the IC team aren't panicking about ructions in the property market, and how Brexit falls have presented a wonderful buying opportunity for breakthrough British biotech shares See acast.com/privacy for privacy and opt-out information.